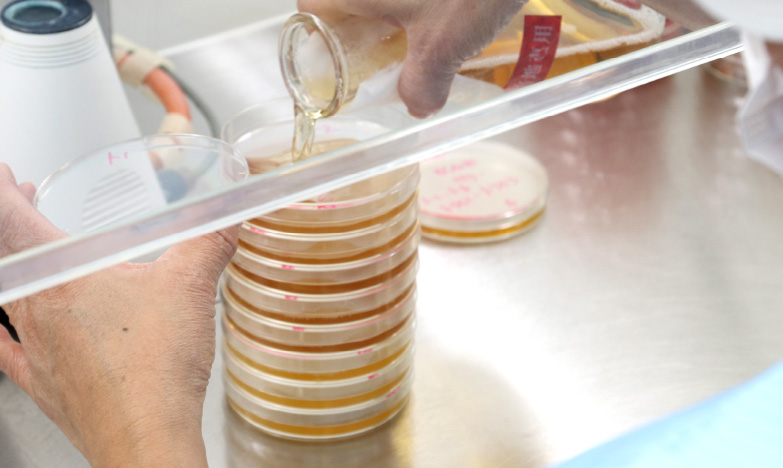

品質管理
お客様からの高い評価。
業界標準を超えた徹底的な品質管理
QUALITY
CONTROL
CONTROL
食の安全は「大前提」。
妥協することなく品質を追求する
人の口に直接入る食品素材を扱うメーカーにとって、安全で安心な製品づくりは絶対条件です。東京フードでは、製品はもとより中間製品や使用する原料に関しても徹底した品質検査を実施しています。例えば、風味や色調などの官能検査や水分・水分活性、粘度、油分・脂肪酸組成、アフラトキシンなどをチェック。細菌検査においても、業界で一般的な大腸菌群や一般性菌数のほか、黄色ブドウ球菌やカビ・酵母といった検査を行っています。また、製造においても、生産管理システムと連動して万全のクオリティ・コントロールを実施。なによりも、検査では、単なる良否判定ではなく「現場とのコミュニケーション」を大切にすることによって、特徴や課題を共有し、全体の品質向上につなげています。東京フードは、つねに「最良」のものをご提供する努力を怠りません。


東京フードの検査体制
-
物性検査
- 実施項目例
- 風味・色調・状態(官能検査)
- 水分・水分活性
- 粘性
- 粒度・粒度分布
- 油分・脂肪酸組成
- 軟化点(環球法)
-
細菌検査
- 実施項目例
- 大腸菌群
- 一般生菌数
- 黄色ブドウ球菌
- カビ・酵母
- 好浸透圧性酵母
- アフラトキシン